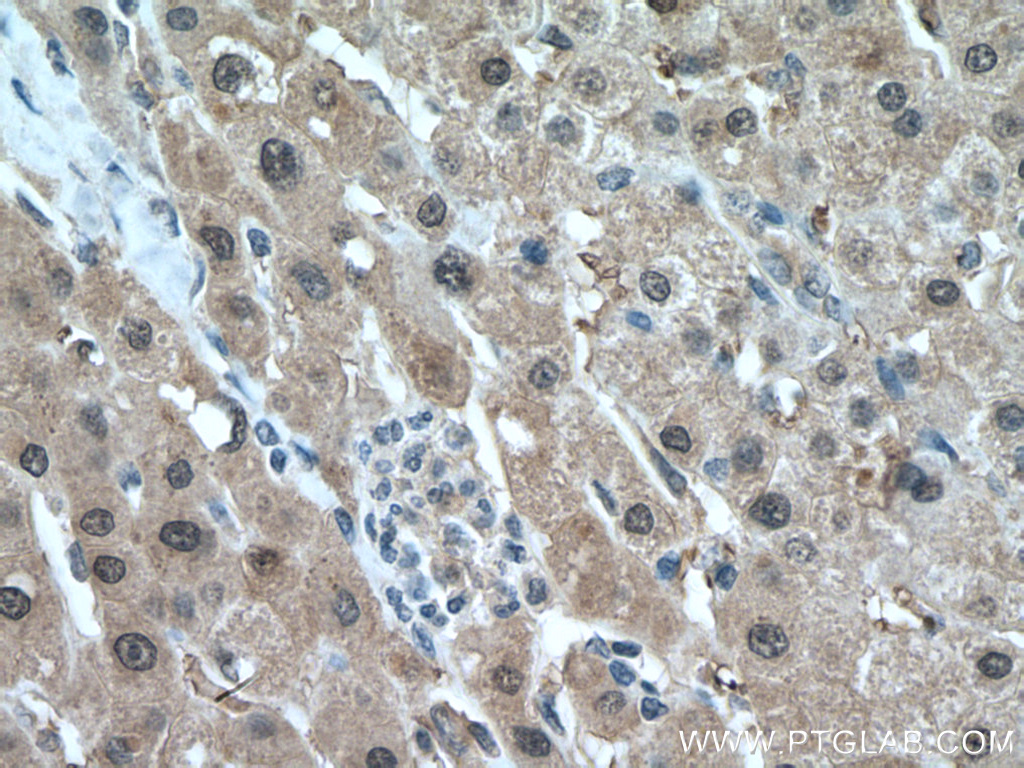

验证数据展示
经过测试的应用
| Positive WB detected in | HEK-293 cells, HEK-293T cells, HeLa cells, SH-SY5Y cells, Neuro-2 cells, mouse brain tissue, mouse liver tissue, rat brain tissue, rat liver tissue, Jurkat cells, human placenta tissue |
| Positive IP detected in | HEK-293 cells, HeLa cells |
| Positive IHC detected in | human liver cancer tissue, human colon tissue, human heart tissue Note: suggested antigen retrieval with TE buffer pH 9.0; (*) Alternatively, antigen retrieval may be performed with citrate buffer pH 6.0 |
| Positive IF-P detected in | mouse brain tissue |
| Positive IF/ICC detected in | HEK-293 cells, HeLa cells |
推荐稀释比
| 应用 | 推荐稀释比 |
|---|---|
| Western Blot (WB) | WB : 1:5000-1:50000 |
| Immunoprecipitation (IP) | IP : 0.5-4.0 ug for 1.0-3.0 mg of total protein lysate |
| Immunohistochemistry (IHC) | IHC : 1:300-1:1200 |
| Immunofluorescence (IF)-P | IF-P : 1:50-1:500 |
| Immunofluorescence (IF)/ICC | IF/ICC : 1:200-1:800 |
| It is recommended that this reagent should be titrated in each testing system to obtain optimal results. | |
| Sample-dependent, Check data in validation data gallery. | |
产品信息
10269-1-AP targets SOD1 in WB, IHC, IF/ICC, IF-P, IP, CoIP, ELISA applications and shows reactivity with human, mouse, rat samples.
| 经测试应用 | WB, IHC, IF/ICC, IF-P, IP, ELISA Application Description |
| 文献引用应用 | WB, IHC, IF, IP, CoIP, ELISA |
| 经测试反应性 | human, mouse, rat |
| 文献引用反应性 | human, mouse, rat, pig, canine, chicken, zebrafish, sheep, goat |
| 免疫原 |
CatNo: Ag0335 Product name: Recombinant human SOD1 protein Source: e coli.-derived, PGEX-4T Tag: GST Domain: 1-154 aa of BC001034 Sequence: MATKAVCVLKGDGPVQGIINFEQKESNGPVKVWGSIKGLTEGLHGFHVHEFGDNTAGCTSAGPHFNPLSRKHGGPKDEERHVGDLGNVTADKDGVADVSIEDSVISLSGDHCIIGRTLVVHEKADDLGKGGNEESTKTGNAGSRLACGVIGIAQ 种属同源性预测 |
| 宿主/亚型 | Rabbit / IgG |
| 抗体类别 | Polyclonal |
| 产品类型 | Antibody |
| 全称 | superoxide dismutase 1, soluble |
| 别名 | ALS1, EC:1.15.1.1, homodimer, hSod1, IPOA |
| 计算分子量 | 16 kDa |
| 观测分子量 | 16-20 kDa |
| GenBank蛋白编号 | BC001034 |
| 基因名称 | SOD1 |
| Gene ID (NCBI) | 6647 |
| RRID | AB_2193750 |
| 偶联类型 | Unconjugated |
| 形式 | Liquid |
| 纯化方式 | Antigen affinity purification |
| UNIPROT ID | P00441 |
| 储存缓冲液 | PBS with 0.02% sodium azide and 50% glycerol, pH 7.3. |
| 储存条件 | Store at -20°C. Stable for one year after shipment. Aliquoting is unnecessary for -20oC storage. |
背景介绍
The enzymatic function of Cu/Zn Superoxide Dismutase (SOD1), previously known as hemocuprein and IPOA, was first characterized in 1969 (PMID: 5389100). SOD1 is commonly known for its ROS scavenging activity, but recent work has uncovered additional roles in modulating metabolism, maintaining redox balance, and regulating transcription. In disease contexts, SOD1 is best-known for its role in a familial form of amyotrophic lateral sclerosis (fALS) (PMID: 10630188). In addition, SOD1 is overexpressed in numerous cancer types, including lung adenocarcinoma, non-small-cell lung cancer , and 70% of primary breast cancers (PMID: 31344643).
实验方案
| Product Specific Protocols | |
|---|---|
| IF protocol for SOD1 antibody 10269-1-AP | Download protocol |
| IHC protocol for SOD1 antibody 10269-1-AP | Download protocol |
| IP protocol for SOD1 antibody 10269-1-AP | Download protocol |
| WB protocol for SOD1 antibody 10269-1-AP | Download protocol |
| Standard Protocols | |
|---|---|
| Click here to view our Standard Protocols |
发表文章
| Species | Application | Title |
|---|---|---|
Cell Stem Cell Artificial extracellular matrix scaffolds of mobile molecules enhance maturation of human stem cell-derived neurons | ||
Bioact Mater Dynamic degradation patterns of porous polycaprolactone/β-tricalcium phosphate composites orchestrate macrophage responses and immunoregulatory bone regeneration | ||
Bioact Mater A two-pronged approach to inhibit ferroptosis of MSCs caused by the iron overload in postmenopausal osteoporosis and promote osseointegration of titanium implant | ||
Nat Struct Mol Biol TDP-43 aggregation induced by oxidative stress causes global mitochondrial imbalance in ALS. | ||
Nat Commun Inflammation mobilizes copper metabolism to promote colon tumorigenesis via an IL-17-STEAP4-XIAP axis. |